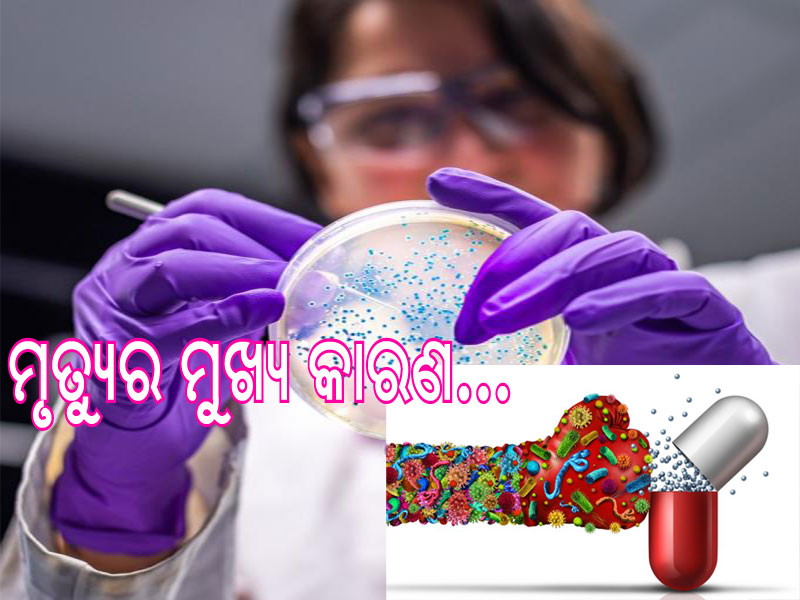

ଓ୍ବାଶିଂଟନ, ୧୯।୧ : ମେଡ଼ିବାଲ ପତ୍ରିକା ଲାନସେଟରେ ପ୍ରକାଶିତ ଏକ ଅଧ୍ୟୟନ ଅନୁଯାୟୀ ୨୦୧୯ରେ ପୃଥିବୀରେ ଆଣ୍ଟିବାୟୋଟିକ-ରେଜିଷ୍ଟାନ୍ସ୍ ବ୍ୟାକ୍ଟେରିଆ ସଂକ୍ରମଣ ଯୋଗୁ ୧୨ ଲକ୍ଷରୁ ଅଧିକ ଲୋକଙ୍କର ମୃତ୍ୟୁ ଘଟିଛି। ସମ୍ପ୍ରତି ଗୋଟିଏ ଦିନରେ ଏହାଯୋଗୁ ୩,୫୦୦ରୁ ଅଧିକ ଲୋକଙ୍କର ମୃତ୍ୟୁ ଘଟୁଛି।
ପୃଥିବୀର ୨୦୪ ଦେଶ ଏବଂ ଅଞ୍ଚଳରେ ହୋଇଥିବା ସର୍ଭେରୁ ଜଣାପଡିଛି ଯେ ଆଣ୍ଟିମାଇକ୍ରୋବାୟଲ ରିଜିଷ୍ଟାନ୍ସ୍ (ଏଏମ୍ଆର୍) ପୃଥିବୀରେ ମୃତ୍ୟୁର ଏକ ପ୍ରମୁଖ କାରର ପାଲଟିଛି। ଏଥିରେ ହେଉଥିବା ମୃତ୍ୟୁ ସଂଖ୍ୟା ଏଚଆଇଭି ଏଡସ କିମ୍ବା ମ୍ୟାଲେରିଆ ତୁଳନାରେ ଅଧିକ ରହିଛି।
ଏହାର ପ୍ରଭାବରେ ଶ୍ୱାସନଳୀ ଏବଂ ରକ୍ତ ପ୍ରବାହ ନଳୀରେ ସଂକ୍ରମଣ ଯୋଗୁ ବହୁ ଲୋକଙକ୍କ ମୃତ୍ୟୁ ଘଟିବାରେ ଲରାଗିଛି। ଏହି ରିପୋର୍ଟରେ ଏଏମ୍ଆର୍ର ମୁକାବିଲା ପାଇଁ ଜରୁରୀ ପଦକ୍ଷେପ ଗ୍ରହଣର ଆବଶ୍ୟକତା ଉପରେ ଗୁରୁତ୍ୱାରୋପ କରାଯାଇଛି। ଏହା ଅନ୍ତର୍ଗତ ସମ୍ପ୍ରତି ଉପଲବ୍ଧ ଆଣ୍ଟିବାୟୋଟିକ ବ୍ୟବହାରକୁ ଅପ୍ଟିମାଇଜ କରିବା, ସଂକ୍ରମଣ ଉପରେ ନଜର ରଖିବା ଏବଂ ନିୟନ୍ତ୍ରଣ କରିବା ପାଇଁ ଅଧିକ ପଦକ୍ଷେପ ନେବା ଏବଂ ନୂତନ ଆଣ୍ଟିବାୟୋଟିକ ଏବଂ ଚିକିତ୍ସା ବିକାଶ ପାଇଁ ଅଧିକ ଅର୍ଥ ପ୍ରଦାନ କରିବା ଆଦି ପଦକ୍ଷେପକୁ ଅନ୍ତର୍ଭୁକ୍ତ କରିବା ଲାଗି କୁହାଯାଇଛି।
ରିପୋର୍ଟରେ ବିଶ୍ୱ ବ୍ୟାପି ଆଣ୍ଟିମାଇକ୍ରୋବାୟଲ ରେଜିଷ୍ଟାନ୍ସ୍ର ପ୍ରକୃତ ମାନକ ପ୍ରକାଶ କରାଯିବା ସହିତ ବିପଦର ମୁକାବିଲା କରିବା ପାଇଁ ଆମକୁ ବର୍ତ୍ତମାନ କାର୍ଯ୍ୟ କରିବାକୁ ପଡିବ ବୋଲି ଏକ ସ୍ପଷ୍ଟ ସଙ୍କେତ ପ୍ରଦାନ କରାଯାଇଛି। ପୂର୍ବ ଆକଳନ କରାଯାଇଥିଲା ଯେ, ୨୦୫୦ ସୁଦ୍ଧା ଆଣ୍ଟିମାଇକ୍ରୋବାୟଲ ରେଜିଷ୍ଟାନ୍ସ୍ ଦ୍ୱାରା ବାର୍ଷିକ ୧୦ ନିୟୁତ ମୃତ୍ୟୁ ଘଟିବ। କିନ୍ତୁ ଆମେ ବର୍ତ୍ତମାନ ନିଶ୍ଚିତ ଭାବରେ ଜାଣିଛୁ ଯେ ଧାର୍ଯ୍ୟ ଆକଳନର ଅଧିକ ନିକଟତର ହେବାରେ ଲାଗିଛୁ। ଏନେଇ ଦୃଢ଼ ପଦକ୍ଷେପ ଗ୍ରହଣର ଆବଶ୍ୟକତା ରହିଥିବା ୱାଶିଂଟନ ବିଶ୍ୱବିଦ୍ୟାଳୟର ହେଲଥ୍ ମ୍ୟାଟ୍ରିକ୍ସ୍ ଏବଂ ଇଭାଲ୍ୟୁଶନର କ୍ରିସ ମୁରେ କହିଛନ୍ତି।
ଗ୍ଲୋବାଲ ରିସର୍ଚ୍ଚ ରିପୋର୍ଟରେ ଦର୍ଶାଯାଇଛି ଯେ, ୨୦୧୯ରେ ୨୦୪ ଦେଶ ତଥା ଅଞ୍ଚଳରେ ୨୩ ପାଥୋଜେନ ଏବଂ ୮୮ ପ୍ୟାଥୋଜେନ-ଡ୍ରଗ ମିଶ୍ରଣ ଯୋଗୁ ଅଧିକ ମୃତ୍ୟୁ ଘଟିଛି। ସର୍ଭେରେ ଡାକ୍ତରଖାନା ପ୍ରଣାଳୀ, ନିରୀକ୍ଷଣ ପ୍ରଣାଳୀ ଏବଂ ଅନ୍ୟାନ୍ୟ ତଥ୍ୟ ଉତ୍ସରୁ ୪୭୧ ନିୟୁତ ଲୋକଙ୍କର ବ୍ୟକ୍ତିଗତ ରେକର୍ଡକୁ ବ୍ୟବହାର କରାଯାଇଥିଲା।
ଏଏମ୍ଆର୍ ଦ୍ୱାରା ଘଟିଥିବା ମୃତ୍ୟୁ ସଂଖ୍ୟା ଗୁଡିକ ଗଣନା ୨୧ ବିଶ୍ୱସ୍ତରୀୟ ଅଞ୍ଚଳ ଏବଂ ସାତଟି ସୁପର-ଅଞ୍ଚଳରେ ସମ୍ପନ୍ନ କରାଯାଇଥିଲା। ଆଣ୍ଟିମାଇକ୍ରୋବାୟଲ ରେଜିଷ୍ଟାନ୍ସ୍ ଦ୍ୱାରା ସୃଷ୍ଟି ହୋଇଥିବା ସମସ୍ୟାର ମୁକାବିଲା ପାଇଁ କ୍ଲିନିକ ଏବଂ ନୀତି ନିର୍ଣ୍ଣୟକାରୀଙ୍କୁ ଉପଯୁକ୍ତ ପଦକ୍ଷେପ ଗ୍ରହଣର ଆବଶ୍ୟକତା ରହିଛି ଅଧ୍ୟୟନରେ ସାମିଲ ହୋଇଥିବା ଖ୍ରୀଷ୍ଟିଆନ ଡୋଲେସେକ କହିଛନ୍ତି।

















